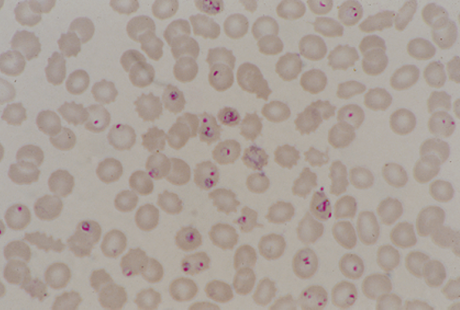
Plasmodium falciparum

Features
- Instant data visualization
- Custom queries & maps
- Exportable graphics
- Map gallery of popular maps
Data topics
VIEW-hub is an open-access data visualization tool for regularly updated vaccine data, covering topics such as Vaccine Introduction & Use, including Vaccine Dosing Schedules, Immunization Coverage & System Strength, and Vaccine Preventable Disease Burden. It also includes country level summary data and topic pages featuring research and analysis on a variety of immunization-related topics.